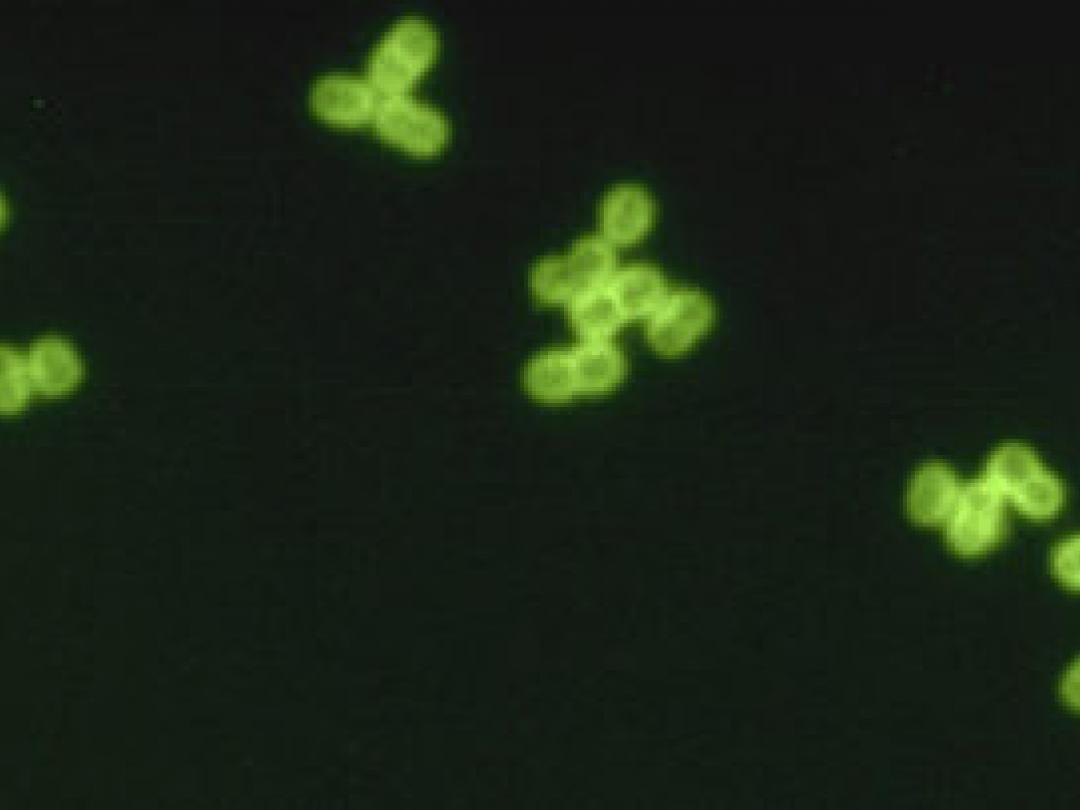

De introductie van een pneumokokkenvaccin dat bescherming biedt tegen 7 serotypes leidde tot een afname van longontstekingen die door deze serotypes veroorzaakt worden. Dat rapporteren Stefan Vestjens (St. Antonius ziekenhuis, Nieuwegein) en medewerkers in Vaccine (2017, online 28 juni).
Eerder onderzoek heeft al laten zien dat sinds de…
Artikelinformatie
Online verschenen op
Citeer dit artikel als
Ned Tijdschr Geneeskd. 2017;161:C3603
Vakgebied

Reacties